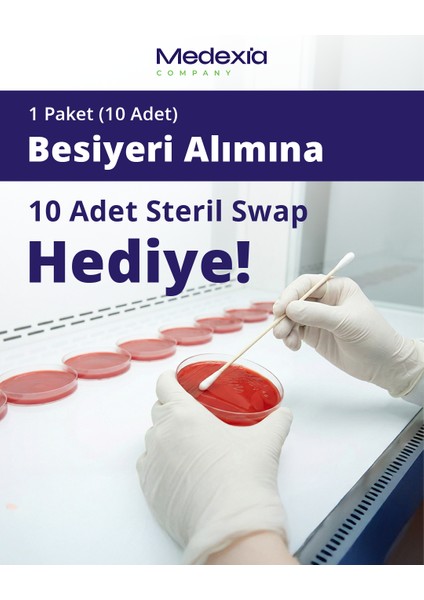

Medexia Company Hazır Koyun Kanlı Besiyeri + 10 Adet Swap
Henüz değerlendirilmemişİlk sen değerlendir
Satıcı: Medexia Company
9,4
9,4Satıcı puanı
Satıcı puanı, müşteri geri bildirimleri ve satıcının sipariş sürecindeki performansı dikkate alınarak hesaplanmaktadır.Ürün Bilgileri
Garanti Süresi (Ay)
3
Yurt Dışı Satış
Yok
Stok Kodu
HBCV0000B0KSZH
Stok Adedi
1.000 adetten az
Medexia Company Hazır Koyun Kanlı Besiyeri + 10 Adet Swap
Hazır Koyun Kanlı Besiyeri + 10 Adet Swap
%5 Koyun Kanlı (Gama Steril Kan)
90 mm Bölmeli Petri
20 ml Hazır Besiyeri IVDR
Steril | pH 7.3 ± 0.2
10’lu Paket Vakumlu Ambalaj
Saklama 2-12 °C
Raf ömrü 3 ay
Koyun Kanlı Besiyeri, klinik örneklerden, gelişimi zor ve zor olmayan mikroorganizmaların izolasyonu ve gelişimi için kullanılan, ayrıca bakterilerin hemolitik reaksiyonlarının da değerlendirildiği oldukça besleyici, genel amaçlı katı bir besiyeridir.
Ürün özellikleri
Garanti Süresi (Ay)
3
Yurt Dışı Satış
Yok
Stok Kodu
HBCV0000B0KSZH
Stok Adedi
1.000 adetten az
Hatalı içerik bildir
Popüler Aramalar